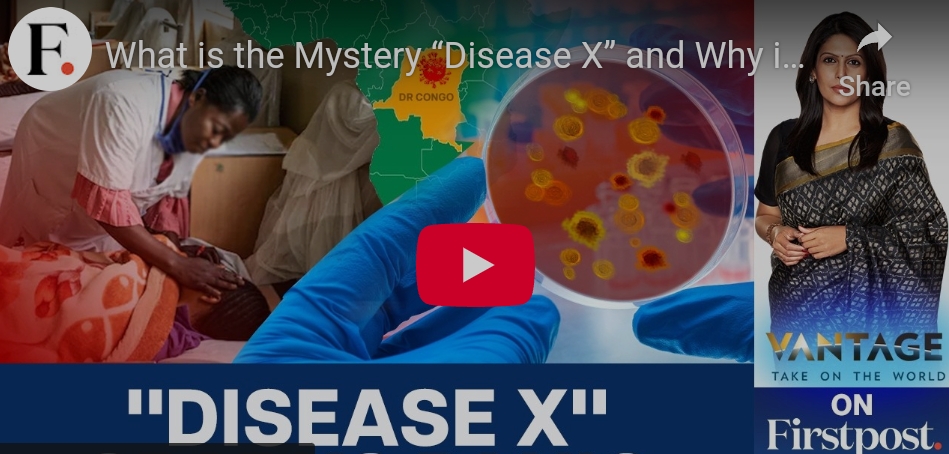

[ Never miss a story — bookmark YAE to stay up-to-date on the best of what YAE has to offer, from viral news videos to scams exposed. ]
Discover more from Your Assignment Editor
Subscribe to get the latest posts sent to your email.
TRENDING NEWS VIDEOS | VIRAL BUZZ: WATCH WHAT EVERYONE IS TALKING ABOUT
[ Never miss a story — bookmark YAE to stay up-to-date on the best of what YAE has to offer, from viral news videos to scams exposed. ]
Subscribe to get the latest posts sent to your email.
We use cookies to improve your experience on our site. By using our site, you consent to cookies.
Manage your cookie preferences below:
Essential cookies enable basic functions and are necessary for the proper function of the website.
These cookies are needed for adding comments on this website.
Statistics cookies collect information anonymously. This information helps us understand how visitors use our website.
Google Analytics is a powerful tool that tracks and analyzes website traffic for informed marketing decisions.
Service URL: policies.google.com (opens in a new window)
Subscribe now to keep reading and get access to the full archive.
Subscribe now to keep reading and get access to the full archive.